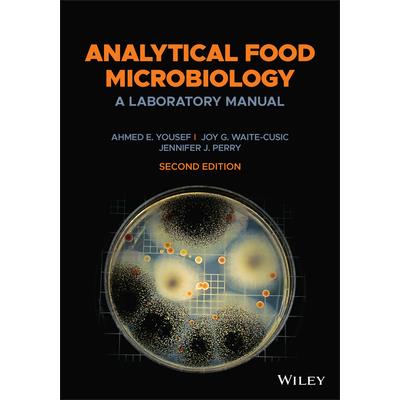
Analytical Food Microbiology

-
Clean Heating Technologies
Ingram 出版This publication provides an overview of clean heating technologies and shares lessons from a pilot
-
Alternative Fuels in Ship Power Plants
Springer 出版Substantiation of Alternative Fuels Utilization.- Modern State of Using Alternative Fuels in Marine
-
Energy and Sustainable Futures
Springer 出版This open access book presents papers displayed in the 2nd International Conference on Energy and S
-
-
Macromolecular Characterization of Hydrocarbons for Sustainable Future
Springer 出版Hydrocarbon Cycle for Sustainable Future: Clean Energy and Green Environment of the Earth.- Explora
-
Motion Correction in MR
Ingram 出版Motion Correction in MR: Correction of Position, Motion, and Dynamic Changes, Volume Eight provides
-
The Application of Computer Techniques to ECG Interpretation
Ingram 出版This book presents some of the latest available information on automated ECG analysis written by ma
-
Electrochemical Energy Conversion and Storage
Wiley-VCH 出版Eines der ersten Lehrb羹cher zum Thema beschreibt die Grundlagen und gibt einen ausgezeichneten ?ber
-
Biogas Combustion Engines for Green Energy Generation
Springer 出版This book deals with the combustion and exhaust emissions of gas engines fueled with green biogas.
-
Life and Research
University 出版Life in a research lab can be daunting, especially for early-career scientists. Personal and profes
-
High-Dimensional Data Analysis with Low-Dimensional Models
Connecting theory with practice, this systematic and rigorous introduction covers the fundamental p
-
Average Current-Mode Control of DC-DC Power Converters
Wiley 出版AVERAGE CURRENT-MODE CONTROL OF DC-DC POWER CONVERTERS An authoritative one-stop guide to the analy
-
The Vortex and the Jet
Springer 出版How and why does a wing generate lift?.- The bound vortex.- Frictionless air cannot provide lift: a
-
The Vortex and the Jet
Springer 出版How and why does a wing generate lift?.- The bound vortex.- Frictionless air cannot provide lift: a
-
Fire Safety Design for Tall Buildings
Ingram 出版Fire Safety Design for Tall Buildings provides structural engineers, architects, and students with
-
Fundamentals of Non-Thermal Processes for Food Preservation
Ingram 出版The ten chapters of this textbook, written in a simple but scientific language, encompass all the n
-
Food Chemistry
Wiley 出版FOOD CHEMISTRY A manual designed for Food Chemistry Laboratory courses that meet Institute of Food
-
The Vitamins
Ingram 出版The Vitamins: Fundamental Aspects in Nutrition and Health, Sixth Edition presents both overviews an
-
Pressure Airships
Ingram 出版Originally published in 1927, this volume is divided into sections on nonrigid and semirigid airshi
-
-
Fossil Fuels in the Arab World
Ingram 出版In his previous books, "Fossil Fuels in the Arab World: Facts and Fiction", and "Fossil Fuels in th
-
Biochemistry, Nutrition, and Therapeutics of Black Cumin Seed
Ingram 出版Biochemistry, Nutrition, and Therapeutics of Black Cumin Seed covers the history of medicinal uses
-
Southern Marine Engineering Desk Reference
Ingram 出版The information contained within this reference compilation is intended to be a helpful guide for t
-
Southern Marine Engineering Desk Reference
Ingram 出版The information contained within this reference compilation is intended to be a helpful guide for t
-
Southern Marine Engineering Desk Reference
Ingram 出版The information contained within this reference compilation is intended to be a helpful guide for t
-
Southern Marine Engineering Desk Reference
Ingram 出版The information contained within this reference compilation is intended to be a helpful guide for t
-
Energy in Perspective
Springer 出版This textbook provides broad coverage of energy supply and use. It discusses how energy is produced
-
Humanizing Healthcare - Human Factors for Medical Device Design
Springer 出版This book introduces human factors engineering (HFE) principles, guidelines, and design methods for
-
-
-
Photon Counting Detectors for X-Ray Imaging
Springer 出版This book first provides readers with an introduction to the underlying physics and state-of-the-ar
-
Machine Learning for Engineers
Ingram 出版This self-contained introduction to machine learning, designed from the start with engineers in min
-
Geospatial Optimization of Solar Energy
Springer 出版This book provides a comprehensive guide on how geographic information systems (GIS) can be used to
-
Mechanical Ventilation Amid the Covid-19 Pandemic
Springer 出版The surge in COVID-19 cases leading to hospitalizations around the world quickly depleted hospital
-
Food Biopolymers: Structural, Functional and Nutraceutical Properties
Springer 出版Food biopolymers: Structural, functional and nutraceutical properties provides valuable coverage of
-
LRFD Bridge Design
Ingram 出版This book examines and explains material from the 9th edition of the AASHTO LRFD Bridge Design Spec
-
Advanced Nanocarbon Materials
Ingram 出版This book provides a well-focused and comprehensive overview of the history and background of nanoc
-
Battery State Estimation
Ingram 出版Batteries are of vital importance for storing intermittent renewable energy for stationary and mobi
-
Hydrate Control in Drilling Mud
Springer 出版This book provides pathways and strategies for mud engineers and drilling students in the future dr
-
The Science of Thai Cuisine
Ingram 出版Lists of the most popular or delicious dishes in the world always include Thai food. Sriracha sauce
-
Analytical Food Microbiology
Wiley 出版The new edition of the highly regarded laboratory manual for courses in food microbiology Analytica
-
Cooling of Rotating Electrical Machines
Ingram 出版Thermal management is an issue with all electrical machines, including electric vehicle drives and
-
Predictive Analytics in Healthcare, Volume1
Ingram 出版Healthcare delivery is progressing into a format wherein analysis of a combination of disease data
-
Drift-Driven Design of Buildings
Ingram 出版This book summarizes the most essential concepts that every engineer designing a new building or ev
-
Recent Developments in Structural Health Monitoring and Assessment - Opportunities and Challenges
Ingram 出版This is a follow up to Health Assessment of Engineered Structures. It incorporates the most recent
-
Evaporative Coolers for the Postharvest Management of Fruits and Vegetables
Ingram 出版Evaporative Coolers for the Postharvest Management of Fruits and Vegetables covers world demand for
-
Multiple Biological Activities of Unconventional Seed Oils
Ingram 出版Multiple Biological Activities of Unconventional Seed Oils brings detailed knowledge concerning the
-
Scheduling and Operation of Virtual Power Plants
Elsevier 出版Scheduling and Operation of Virtual Power Plants: Technical Challenges and Electricity Markets prov
熱門搜尋
搜尋:新闻概览华为应用提示风险解决多少钱 ,全館搜尋共計68981筆,頁數429/1438
- 篩選
-
排序
- 圖片式
- 條列式
-
館別
-
大分類
-
購買狀態
-
作者
-
出版社
-
品牌
-
商品規格
-
出版日期
-
價格區間
-
運送方式